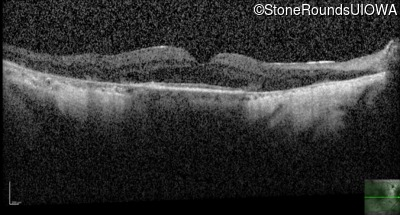
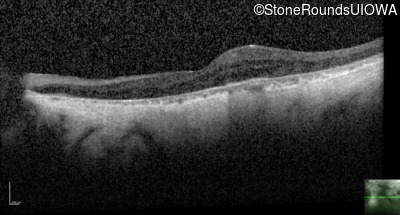

Case
SR1100
Student Mode
XL Choroideremia (IIIA1a)
Male
Male
Hidden
SR1100
Student Mode
XL Choroideremia (IIIA1a)
Male
Male
History
This 54 year old man first experienced some reduction in his night vision at age 32. He had been treated with chloroquine for malaria for two years in his early 20s.
Diagnosis & molecular findings
| Disease | Gene | Allele 1 variant(s) | Allele 2 variant(s) | Inheritance mode |
|---|---|---|---|---|
| XL Choroideremia | CHM | Duplication Exons 6-8 | XL |